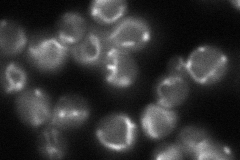

View description
Mitochondrial NADP-specific isocitrate dehydrogenase, catalyzes the oxidation of isocitrate to alpha-ketoglutarate; not required for mitochondrial respiration and may function to divert alpha-ketoglutarate to biosynthetic processes
Localization:
Intensity:
Fold change:
Significance:
-
C’ GFP library in SD

mitochondria194.6 -
N' NOP1pr-GFP in SD

mitochondria275.722 -
N' TEF2pr-mCherry in SD

punctate109.554 -
N' NATIVEpr-GFP in SD
mitochondria102.858 -
N' TEF2pr-VC and Cyto-VN in SD

#N/A0 -
C’ GFP library in SD+DTT

mitochondria217.81.11No -
C’ GFP library in SD+H2O2

mitochondria222.91.14No -
C’ GFP library in Starvation Media

mitochondria117.410.6No -
C’ GFP library on the background of Pup2-DaMP

mitochondria -
C’ GFP library on the background of CCT mutant

mitochondria210.8221.08332No
